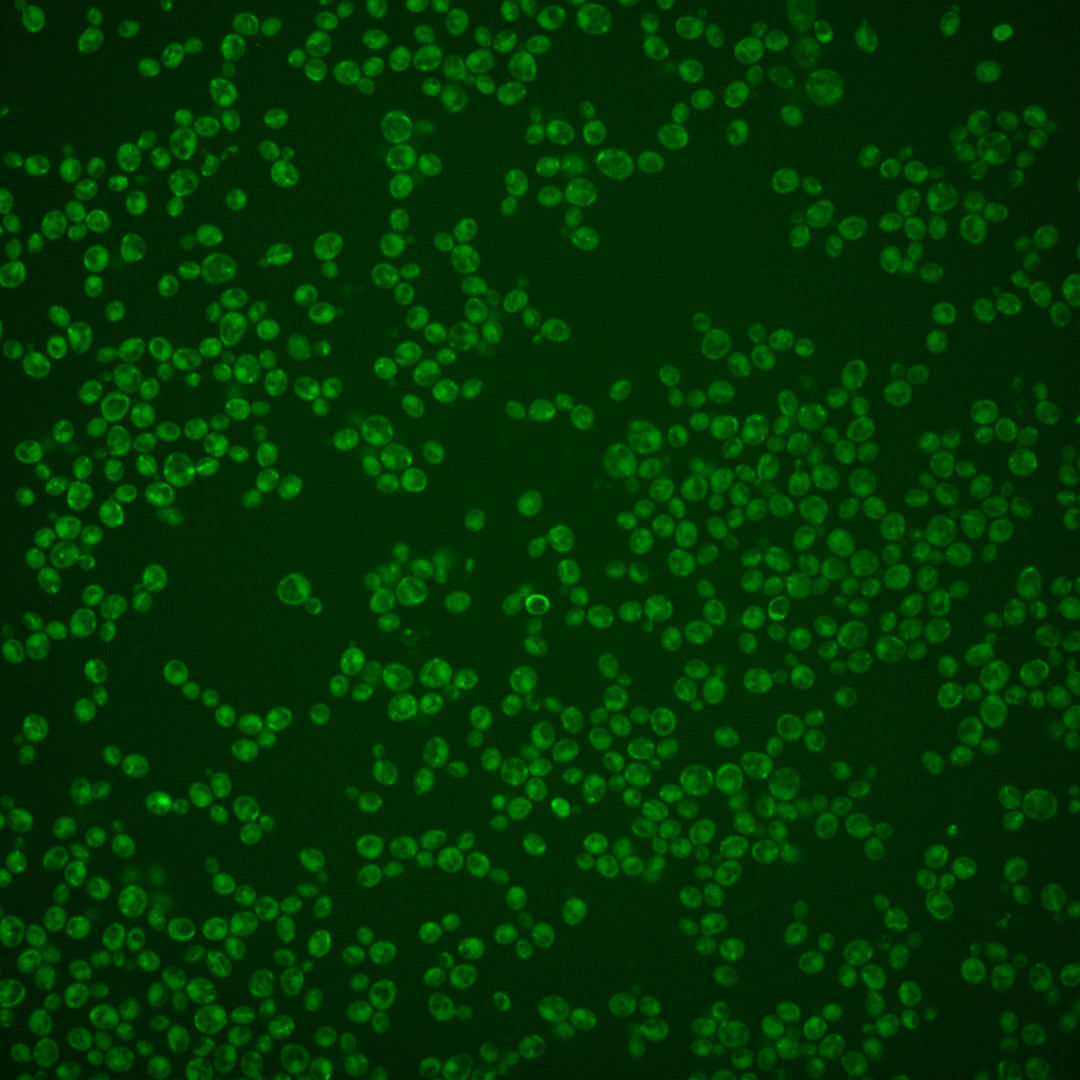
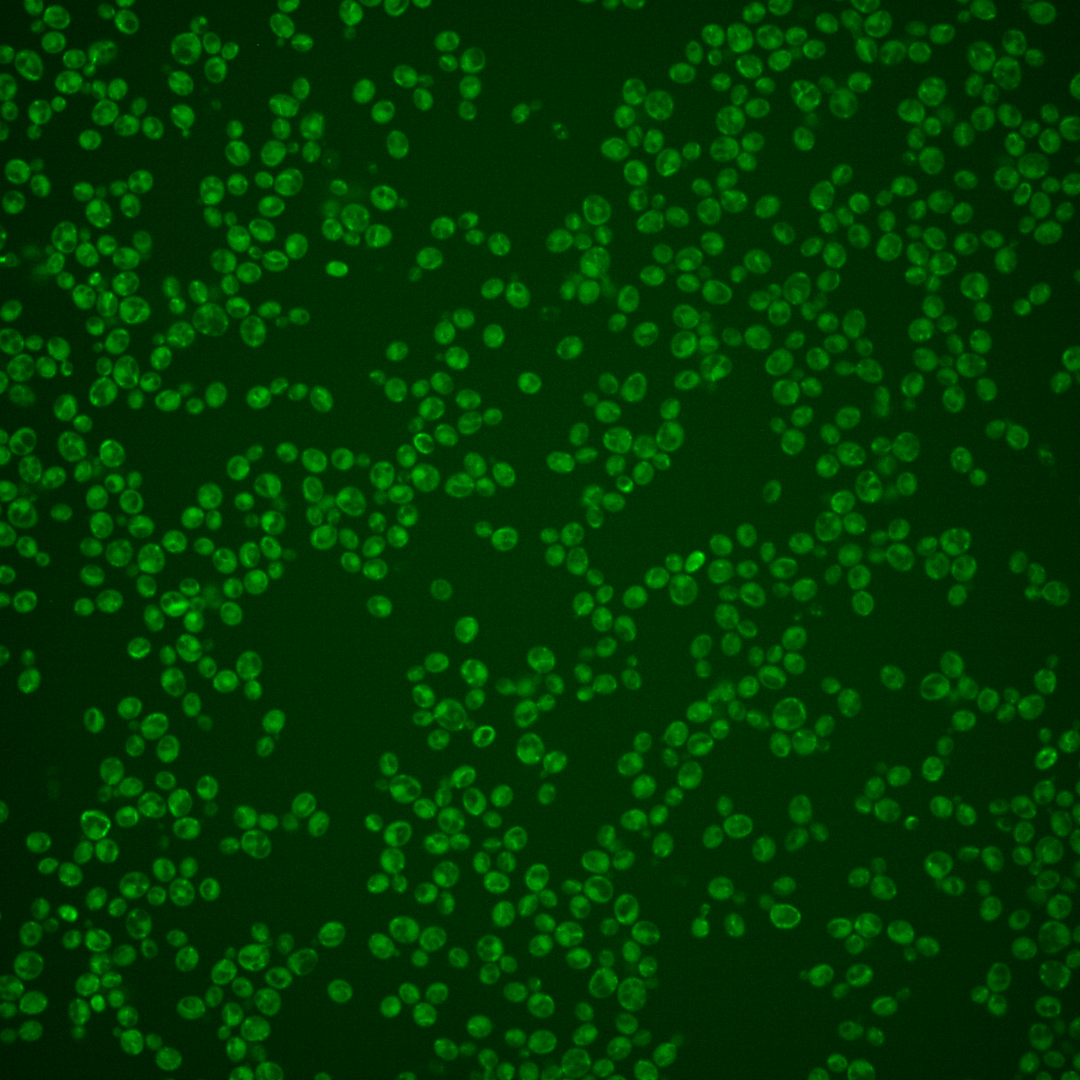
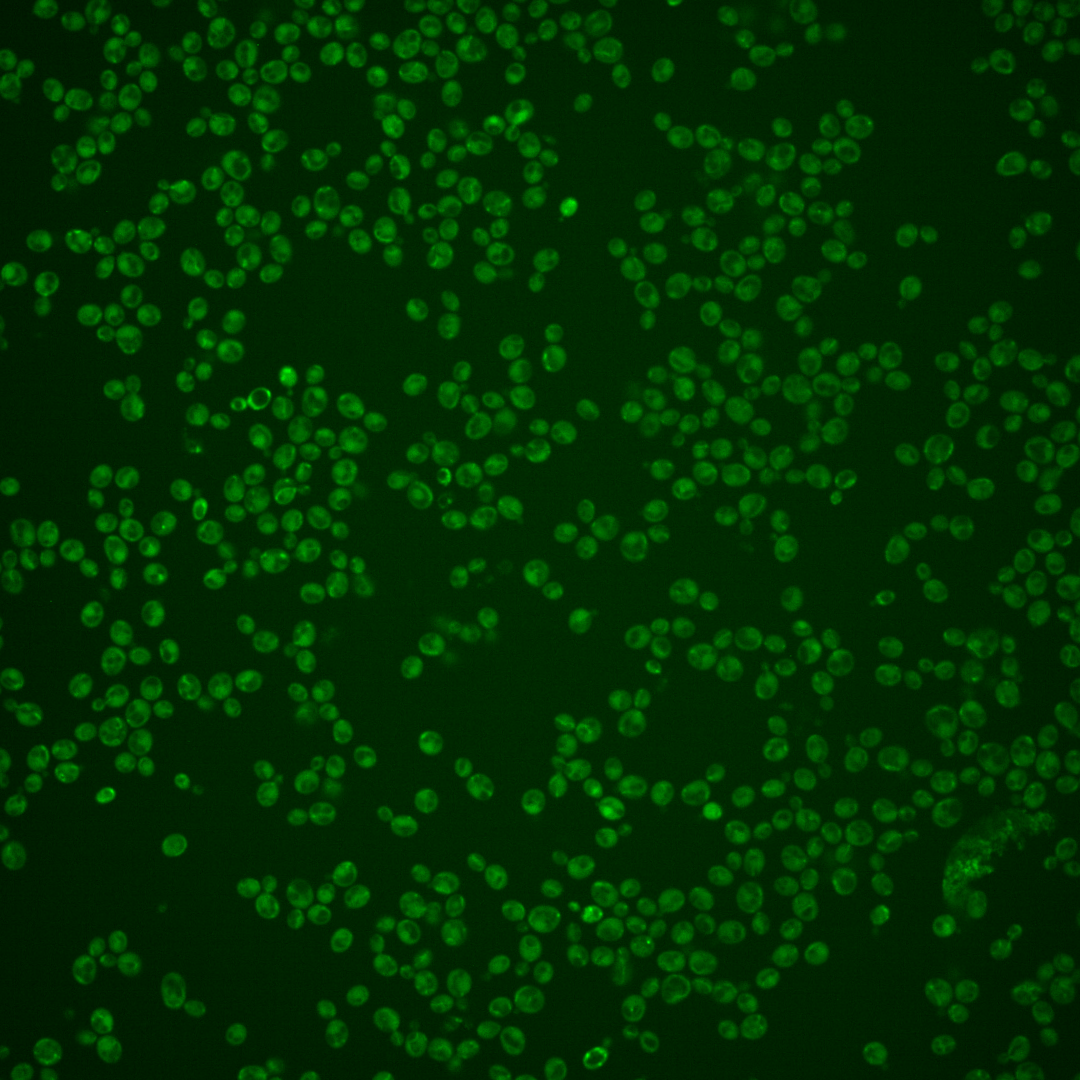

| Standard name | |
|---|---|
| Human Ortholog | |
| Description | One of four subunits of the ESCRT-III complex; forms an endosomal sorting complex required for transport III (ESCRT-III) subcomplex with Did4p; involved in the sorting of transmembrane proteins into the multivesicular body (MVB) pathway |
Micrographs




















































































Sub-cellular Localization
Yeast GFP Assignment
Protein Abundance
Localization Change
External localization resources
| ensLOC | DeepLoc | |||||||||||||||||||||||
|---|---|---|---|---|---|---|---|---|---|---|---|---|---|---|---|---|---|---|---|---|---|---|---|---|
| Localization | WT1 | WT2 | WT3 | RAP60 | RAP140 | RAP220 | RAP300 | RAP380 | RAP460 | RAP540 | RAP620 | RAP700 | HU80 | HU120 | HU160 | rpd3Δ_1 | rpd3Δ_2 | rpd3Δ_3 | WT1 | WT2 | WT3 | AF100 | AF140 | AF180 |
| Cortical Patches | – | 3 | 1 | 0 | 0 | 0 | 0 | 0 | 0 | 0 | 0 | 0 | 2 | 1 | 1 | 5 | 6 | – | 1 | 9 | 9 | 7 | 7 | 8 |
| Bud | – | 5 | 14 | 6 | 10 | 21 | 27 | 31 | 29 | 20 | 29 | 22 | 1 | 0 | 0 | 9 | 9 | – | 0 | 4 | 1 | 3 | 3 | 9 |
| Bud Neck | – | 3 | 2 | 0 | 1 | 3 | 1 | 1 | 0 | 0 | 0 | 1 | 2 | 6 | 2 | 4 | 10 | – | 0 | 4 | 2 | 4 | 6 | 8 |
| Bud Site | – | 1 | 1 | 0 | 0 | 11 | 8 | 11 | 8 | 7 | 18 | 4 | 0 | 0 | 0 | 1 | 1 | – | – | – | – | – | – | – |
| Cell Periphery | – | 3 | 0 | 3 | 1 | 3 | 2 | 1 | 1 | 4 | 1 | 2 | 2 | 2 | 2 | 1 | 10 | – | 1 | 2 | 1 | 1 | 1 | 2 |
| Cytoplasm | – | 224 | 143 | 126 | 78 | 92 | 67 | 46 | 24 | 14 | 26 | 23 | 181 | 183 | 242 | 124 | 120 | – | 2 | 104 | 43 | 32 | 49 | 89 |
| Endoplasmic Reticulum | – | 3 | 1 | 0 | 0 | 1 | 1 | 1 | 3 | 2 | 0 | 1 | 10 | 5 | 2 | 19 | 10 | – | 0 | 2 | 2 | 6 | 6 | 6 |
| Endosome | – | 15 | 14 | 10 | 13 | 2 | 0 | 9 | 1 | 4 | 0 | 1 | 3 | 6 | 7 | 24 | 25 | – | 3 | 30 | 25 | 8 | 10 | 13 |
| Golgi | – | 0 | 0 | 1 | 0 | 0 | 0 | 0 | 0 | 0 | 0 | 0 | 1 | 0 | 0 | 2 | 2 | – | 0 | 3 | 0 | 1 | 3 | 5 |
| Mitochondria | – | 65 | 81 | 96 | 177 | 440 | 472 | 470 | 380 | 434 | 514 | 443 | 0 | 1 | 0 | 37 | 17 | – | 32 | 176 | 183 | 118 | 111 | 117 |
| Nucleus | – | 0 | 2 | 3 | 1 | 6 | 8 | 12 | 8 | 4 | 8 | 1 | 2 | 1 | 1 | 1 | 5 | – | 0 | 0 | 0 | 0 | 1 | 1 |
| Nuclear Periphery | – | 2 | 0 | 0 | 1 | 0 | 1 | 0 | 1 | 8 | 4 | 9 | 0 | 0 | 0 | 1 | 0 | – | 0 | 0 | 0 | 0 | 0 | 1 |
| Nucleolus | – | 0 | 0 | 0 | 0 | 1 | 1 | 7 | 4 | 1 | 3 | 3 | 0 | 0 | 0 | 0 | 0 | – | 0 | 0 | 1 | 0 | 1 | 0 |
| Peroxisomes | – | 7 | 11 | 15 | 2 | 8 | 10 | 10 | 9 | 9 | 4 | 8 | 0 | 0 | 2 | 12 | 1 | – | 0 | 1 | 7 | 3 | 2 | 3 |
| SpindlePole | – | 13 | 23 | 25 | 19 | 22 | 26 | 40 | 28 | 33 | 24 | 13 | 7 | 10 | 6 | 50 | 45 | – | 1 | 25 | 27 | 6 | 5 | 10 |
| Vac/Vac Membrane | – | 11 | 4 | 3 | 14 | 13 | 8 | 10 | 9 | 17 | 13 | 12 | 0 | 5 | 9 | 12 | 14 | – | 1 | 17 | 6 | 17 | 27 | 27 |
| Unique Cell Count | 315 | 249 | 238 | 258 | 504 | 521 | 526 | 409 | 463 | 534 | 462 | 204 | 210 | 258 | 241 | 234 | 46 | 395 | 327 | 217 | 244 | 318 | ||
| Labelled Cell Count | 355 | 297 | 288 | 317 | 623 | 632 | 649 | 505 | 557 | 644 | 543 | 211 | 220 | 274 | 302 | 275 | 46 | 395 | 327 | 217 | 244 | 318 | ||
Yeast GFP Assignment
Protein Abundance
| Screen | WT1 | WT2 | WT3 | RAP60 | RAP140 | RAP220 | RAP300 | RAP380 | RAP460 | RAP540 | RAP620 | RAP700 | HU80 | HU120 | HU160 | rpd3Δ_1 | rpd3Δ_2 | rpd3Δ_3 | AF100 | AF140 | AF180 |
|---|---|---|---|---|---|---|---|---|---|---|---|---|---|---|---|---|---|---|---|---|---|
| Mean Cell GFP Intensity (1e-4) | – | 3.9 | 3.8 | 3.7 | 3.5 | 3.4 | 3.0 | 3.4 | 3.1 | 3.0 | 3.1 | 3.2 | 5.4 | 4.9 | 4.9 | 5.0 | 5.0 | 4.8 | 5.6 | 5.8 | 5.8 |
| Std Deviation (1e-4) | – | 0.6 | 1.3 | 1.3 | 1.6 | 0.9 | 1.2 | 1.5 | 0.9 | 0.6 | 1.0 | 0.8 | 1.5 | 1.1 | 1.0 | 1.0 | 1.3 | 1.1 | 1.8 | 1.7 | 2.3 |
| Intensity Change (Log2) | – | – | – | -0.05 | -0.09 | -0.14 | -0.33 | -0.14 | -0.27 | -0.32 | -0.28 | -0.24 | 0.53 | 0.37 | 0.38 | 0.4 | 0.41 | 0.35 | 0.58 | 0.62 | 0.62 |
Localization Change
| Localization | RAP60 | RAP140 | RAP220 | RAP300 | RAP380 | RAP460 | RAP540 | RAP620 | RAP700 | HU80 | HU120 | HU160 | rpd3Δ_1 | rpd3Δ_2 | rpd3Δ_3 |
|---|---|---|---|---|---|---|---|---|---|---|---|---|---|---|---|
| Actin | – | – | – | – | – | – | – | – | – | – | – | – | – | – | – |
| Bud | – | – | – | – | – | – | – | – | – | – | – | – | 0 | 0 | – |
| Bud Neck | – | – | – | – | – | – | – | – | – | – | – | – | 0 | 0 | – |
| Bud Site | – | – | – | – | – | – | – | – | – | – | – | – | 0 | 0 | – |
| Cell Periphery | – | – | – | – | – | – | – | – | – | – | – | – | 0 | 0 | – |
| Cyto | – | – | – | – | – | – | – | – | – | – | – | – | – | – | – |
| Endoplasmic Reticulum | – | – | – | – | – | – | – | – | – | – | – | – | 0 | 0 | – |
| Endosome | – | – | – | – | – | – | – | – | – | – | – | – | 0 | 0 | – |
| Golgi | – | – | – | – | – | – | – | – | – | – | – | – | 0 | 0 | – |
| Mitochondria | – | – | – | – | – | – | – | – | – | – | – | – | 0 | 0 | – |
| Nuclear Periphery | – | – | – | – | – | – | – | – | – | – | – | – | 0 | 0 | – |
| Nuc | – | – | – | – | – | – | – | – | – | – | – | – | – | – | – |
| Nucleolus | – | – | – | – | – | – | – | – | – | – | – | – | 0 | 0 | – |
| Peroxisomes | – | – | – | – | – | – | – | – | – | – | – | – | 0 | 0 | – |
| SpindlePole | – | – | – | – | – | – | – | – | – | – | – | – | 0 | 0 | – |
| Vac | – | – | – | – | – | – | – | – | – | – | – | – | – | – | – |
| Cortical Patches | – | – | – | – | – | – | – | – | – | – | – | – | 0 | 0 | – |
| Cytoplasm | – | – | – | – | – | – | – | – | – | – | – | – | 0 | 0 | – |
| Nucleus | – | – | – | – | – | – | – | – | – | – | – | – | 0 | 0 | – |
| Vacuole | – | – | – | – | – | – | – | – | – | – | – | – | 2.1 | 2.5 | – |
External localization resources
Images






























Protein Concentration and Protein Localization Data
| R1 | R2 | R3 | ||||||||||||||||
|---|---|---|---|---|---|---|---|---|---|---|---|---|---|---|---|---|---|---|
| G1 Pre-START | G1 Post-START | S/G2 | Metaphase | Anaphase | Telophase | G1 Pre-START | G1 Post-START | S/G2 | Metaphase | Anaphase | Telophase | G1 Pre-START | G1 Post-START | S/G2 | Metaphase | Anaphase | Telophase | |
| Concentration | 0.4026 | 0.476 | 0.5249 | 0.2809 | 0.3456 | 0.5367 | 1.5677 | 2.4794 | 2.1571 | 2.3653 | 1.8418 | 2.6958 | 0.227 | 0.4791 | 0.4116 | 0.3655 | 0.3304 | 0.4707 |
| Actin | 0.0081 | 0.0032 | 0.0044 | 0.0057 | 0.0021 | 0.0199 | 0.0266 | 0.0457 | 0.0113 | 0.0051 | 0.0499 | 0.0132 | 0.0099 | 0.0076 | 0.0092 | 0.0126 | 0.0044 | 0.007 |
| Bud | 0.0018 | 0.0031 | 0.0075 | 0.0026 | 0.0005 | 0.0028 | 0.0015 | 0.0039 | 0.0061 | 0.0011 | 0.0027 | 0.0021 | 0.0014 | 0.0039 | 0.0025 | 0.0012 | 0.0026 | 0.0015 |
| Bud Neck | 0.002 | 0.0013 | 0.0066 | 0.0013 | 0.0007 | 0.0034 | 0.0024 | 0.0042 | 0.003 | 0.0011 | 0.0013 | 0.0146 | 0.0018 | 0.0043 | 0.0032 | 0.0203 | 0.0021 | 0.0055 |
| Bud Periphery | 0.0041 | 0.0081 | 0.012 | 0.009 | 0.0016 | 0.0083 | 0.0048 | 0.0113 | 0.0144 | 0.0024 | 0.0066 | 0.0069 | 0.0041 | 0.0082 | 0.0085 | 0.0044 | 0.0097 | 0.0064 |
| Bud Site | 0.0061 | 0.0245 | 0.0117 | 0.0101 | 0.0005 | 0.0025 | 0.0059 | 0.0576 | 0.0269 | 0.0019 | 0.0023 | 0.0029 | 0.0085 | 0.0141 | 0.0065 | 0.0035 | 0.0024 | 0.0017 |
| Cell Periphery | 0.0017 | 0.0019 | 0.0013 | 0.0015 | 0.0003 | 0.0011 | 0.0028 | 0.0031 | 0.0023 | 0.0007 | 0.0022 | 0.0023 | 0.0012 | 0.001 | 0.0021 | 0.0006 | 0.0018 | 0.0022 |
| Cytoplasm | 0.0489 | 0.0524 | 0.0673 | 0.0388 | 0.0219 | 0.0419 | 0.0998 | 0.0674 | 0.1053 | 0.0515 | 0.0439 | 0.1058 | 0.0465 | 0.0409 | 0.0625 | 0.0228 | 0.0506 | 0.0541 |
| Cytoplasmic Foci | 0.084 | 0.0802 | 0.0861 | 0.0939 | 0.0729 | 0.0879 | 0.092 | 0.1072 | 0.1391 | 0.0687 | 0.1034 | 0.1101 | 0.109 | 0.1239 | 0.0897 | 0.1196 | 0.1407 | 0.1297 |
| Eisosomes | 0.0008 | 0.0007 | 0.0007 | 0.0008 | 0.0004 | 0.0005 | 0.0045 | 0.0019 | 0.0012 | 0.0008 | 0.002 | 0.0009 | 0.0011 | 0.0005 | 0.0008 | 0.0003 | 0.0004 | 0.0004 |
| Endoplasmic Reticulum | 0.0071 | 0.0051 | 0.004 | 0.0031 | 0.0024 | 0.0019 | 0.0054 | 0.0034 | 0.0041 | 0.0011 | 0.0036 | 0.0018 | 0.0027 | 0.0017 | 0.0026 | 0.0012 | 0.0011 | 0.0031 |
| Endosome | 0.1413 | 0.1358 | 0.0885 | 0.1348 | 0.0975 | 0.0862 | 0.1078 | 0.1233 | 0.1126 | 0.0362 | 0.0817 | 0.078 | 0.1612 | 0.1285 | 0.0936 | 0.0846 | 0.1531 | 0.1322 |
| Golgi | 0.0429 | 0.044 | 0.0312 | 0.0269 | 0.0393 | 0.0341 | 0.046 | 0.0553 | 0.042 | 0.0486 | 0.0767 | 0.0383 | 0.0547 | 0.0694 | 0.0352 | 0.0263 | 0.042 | 0.0422 |
| Lipid Particles | 0.0424 | 0.0216 | 0.0249 | 0.0181 | 0.0329 | 0.0462 | 0.0349 | 0.0175 | 0.0199 | 0.0041 | 0.0384 | 0.0201 | 0.0491 | 0.013 | 0.0198 | 0.0634 | 0.0137 | 0.0317 |
| Mitochondria | 0.3629 | 0.4205 | 0.3929 | 0.4829 | 0.4278 | 0.402 | 0.2403 | 0.2765 | 0.2682 | 0.3332 | 0.3343 | 0.3321 | 0.3996 | 0.4376 | 0.4351 | 0.468 | 0.4302 | 0.3892 |
| None | 0.1545 | 0.1271 | 0.1835 | 0.1151 | 0.1583 | 0.178 | 0.2637 | 0.1381 | 0.1721 | 0.3477 | 0.1715 | 0.1844 | 0.0818 | 0.0559 | 0.1433 | 0.0852 | 0.0499 | 0.093 |
| Nuclear Periphery | 0.0112 | 0.0025 | 0.0027 | 0.0013 | 0.0295 | 0.0009 | 0.0098 | 0.0013 | 0.002 | 0.0005 | 0.0006 | 0.0005 | 0.002 | 0.0006 | 0.0011 | 0.0005 | 0.0005 | 0.002 |
| Nucleolus | 0.0036 | 0.0029 | 0.0016 | 0.0024 | 0.0006 | 0.001 | 0.0017 | 0.0009 | 0.0008 | 0.0007 | 0.001 | 0.0009 | 0.0026 | 0.0008 | 0.0018 | 0.0004 | 0.0009 | 0.0018 |
| Nucleus | 0.0109 | 0.0026 | 0.0034 | 0.0023 | 0.0127 | 0.0015 | 0.0018 | 0.0012 | 0.0011 | 0.0011 | 0.001 | 0.001 | 0.002 | 0.0011 | 0.0019 | 0.0004 | 0.0018 | 0.0026 |
| Peroxisomes | 0.0377 | 0.0353 | 0.0492 | 0.0289 | 0.0865 | 0.0675 | 0.0306 | 0.0655 | 0.0514 | 0.0875 | 0.0627 | 0.0707 | 0.042 | 0.0751 | 0.0566 | 0.0779 | 0.0733 | 0.0751 |
| Punctate Nuclear | 0.0064 | 0.0022 | 0.006 | 0.003 | 0.0008 | 0.0026 | 0.004 | 0.0052 | 0.0018 | 0.0005 | 0.0006 | 0.001 | 0.0042 | 0.0005 | 0.0017 | 0.0018 | 0.0012 | 0.0033 |
| Vacuole | 0.0154 | 0.019 | 0.0104 | 0.0124 | 0.0054 | 0.0064 | 0.0096 | 0.0058 | 0.0106 | 0.0038 | 0.0101 | 0.0086 | 0.0106 | 0.0086 | 0.0152 | 0.0029 | 0.0133 | 0.0113 |
| Vacuole Periphery | 0.0063 | 0.0059 | 0.0041 | 0.0052 | 0.0054 | 0.0034 | 0.004 | 0.0034 | 0.0037 | 0.0015 | 0.0033 | 0.0036 | 0.0039 | 0.0028 | 0.007 | 0.0024 | 0.0043 | 0.0043 |
Sequencing Data
| R1 | R2 | |||||||||
|---|---|---|---|---|---|---|---|---|---|---|
| G1 Post-START | S/G2 | Metaphase | Anaphase | Telophase | G1 Post-START | S/G2 | Metaphase | Anaphase | Telophase | |
| Gene Expression | 3.2693 | 5.8452 | 9.7591 | 12.7769 | 18.0151 | 3.2675 | 8.1263 | 11.4681 | 10.6711 | 9.5598 |
| Translational Efficiency | 16.0356 | 8.3164 | 4.8197 | 4.2594 | 2.9194 | 15.2625 | 6.3363 | 4.0969 | 4.3749 | 5.0008 |
Hit Data
| Dataset | Hit |
|---|---|
| Protein Concentration | ✔ |
| Protein Localization | ✘ |
| Gene Expression | ✔ |
| Translational Efficiency | ✘ |
Endocytosis
| Temp | Actin Patch (Sac6-tdTomato) | Cortical Patch (Sla1-GFP) | Late Endosome (Snf7-GFP) | Vacuole (Vph1-GFP) |
|---|---|---|---|---|
| 37℃ | ||||
| RT |
Cell Cycle Omics
CYCLoPs (Vps24-GFP)
| Gene / Allele | Actin Patch (Sac6-tdTomato) | Cortical Patch (Sla1-GFP) | Late Endosome (Snf7-GFP) | Vacuole (Sac6-tdTomato) |
|---|
| Gene | Images |
|---|
| Gene | Images |
|---|
Images are not yet available
Images are not yet available